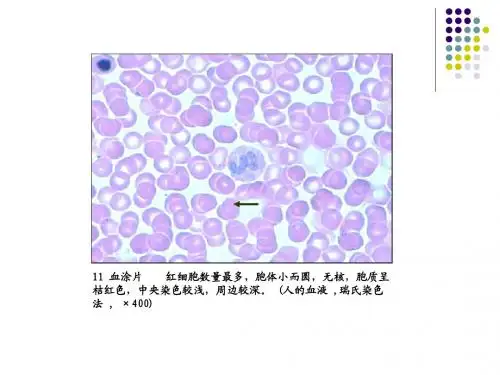

组织学与胚胎学复习资料
- 格式:doc
- 大小:58.00 KB
- 文档页数:12

---------------------------------------------------------------最新资料推荐------------------------------------------------------组织学与胚胎学复习笔记第一章组织学绪论一、组织学和胚胎学的研究内容;组织学定义组织定义二、组织学常用研究技术:1、光镜技术:LM 技术(0.2 m)(1)石蜡切片术(最常用切片术):取材,固定,脱水,透明,包埋,切片,染色,封片 H-E 染色(苏木精-伊红染色)定义嗜碱性:嗜酸性:在细胞中,粗面内质网,游离核糖体和高尔基体均为嗜碱性,故当这些细胞器丰富时,细胞嗜碱性;而溶酶体和线粒体为嗜酸性,故他们丰富时细胞嗜酸性。
硝酸银染色:异染性:有些组织成分用甲苯胺蓝等碱性染料染色后不显蓝色而成紫红色,这种现象称异染性。
(2)其它常用的制片方法:冰冻切片:用恒冷切片机,将组织迅速冻结之即切片,他能保留组织细胞内的脂类成分和某些酶活性,可做细胞酶化学染色观察。
涂片:将体液成分或器官组织的刮取物涂在载玻片上,制成薄膜,经1 / 3过固定染色后进行观察,如:血涂片、骨髓涂片等。
2、电镜技术:EM 技术(0.2nm)(1)透射电镜术:用来观察组织细胞内部结构;被重金属盐染色的部位,在电镜照片上呈黑色或深灰色,称该结构为高电子密度,反之呈浅灰色,为低电子密度。
(2)扫描电镜术:观察组织表面形态结构 3、组织化学技术:(1)一般组织化学术原理:在切片上加某种试剂,和组织中的待检物质发生化学反应,其最终产物为有色沉淀物或重金属沉淀,以便用显微镜观察。
PAS 反应:过碘酸希夫反应,显示多糖和糖蛋白的糖链,紫红色反应产物为阳性。
(2)免疫组织化学术原理:根据抗原抗体特异性结合,使标记抗体与待测抗原特异性结合,检测标本中的抗原。
(3)原位杂交术原理核酸分子杂交组织化学术 4、细胞培养与组织工程 1、组织学是研究人体细微结构及相关功能的一门科学,主要手段是用显微镜观察器官,组织和细胞以及细胞外基质的结构 2、组织:---------------------------------------------------------------最新资料推荐------------------------------------------------------ 有形态和功能相同或相似的细胞群以及多少不等的细胞外基质构成的结构是组织。

组织学与胚胎学题库及答案# 一、单选题。
题目1:光镜下所见的纹状缘或刷状缘,电镜下是()。
A. 微管。
B. 微丝。
C. 纤毛。
D. 微绒毛。
答案:D。
解析:微绒毛是细胞游离面伸出的许多细小指状突起,在光镜下,小肠上皮细胞的微绒毛密集排列整齐,形成纹状缘;而肾小管上皮细胞的微绒毛则形成刷状缘。
微管是细胞骨架的组成成分之一,主要参与细胞的形态维持、细胞运动等;微丝主要与细胞的收缩、运动等功能有关;纤毛比微绒毛粗且长,具有节律性摆动的功能。
所以光镜下所见的纹状缘或刷状缘,电镜下是微绒毛,答案选D。
题目2:疏松结缔组织中最主要的细胞是()。
A. 成纤维细胞。
B. 巨噬细胞。
C. 浆细胞。
D. 肥大细胞。
答案:A。
解析:成纤维细胞是疏松结缔组织中最主要的细胞,它具有合成和分泌胶原蛋白、弹性蛋白等纤维成分以及糖胺多糖等基质成分的功能,对疏松结缔组织的结构和功能维持起着关键作用。
巨噬细胞具有吞噬、免疫等功能;浆细胞主要参与体液免疫,能合成和分泌免疫球蛋白;肥大细胞与过敏反应等有关。
所以疏松结缔组织中最主要的细胞是成纤维细胞,答案选A。
题目3:下列哪种细胞不属于单核吞噬细胞系统()。
A. 血液中的单核细胞。
B. 结缔组织中的巨噬细胞。
C. 神经组织中的小胶质细胞。
D. 血液中的中性粒细胞。
答案:D。
解析:单核吞噬细胞系统包括血液中的单核细胞、结缔组织中的巨噬细胞、神经组织中的小胶质细胞、肝中的枯否细胞、肺中的尘细胞等。
这些细胞都具有吞噬功能,在机体的防御、免疫等过程中发挥重要作用。
而中性粒细胞虽然也有吞噬功能,但它不属于单核吞噬细胞系统。
所以答案选D。
# 二、多选题。
题目1:上皮组织的特点包括()。
A. 细胞多,间质少。
B. 细胞有极性。
C. 无血管。
D. 有丰富的神经末梢。
答案:ABCD。
解析:上皮组织的特点主要有:细胞多且排列紧密,间质少;细胞具有极性,即细胞的一端朝向体表或管腔等的游离面,另一端则借助基膜与深部的结缔组织相连;上皮组织内无血管,其营养物质通过基膜从结缔组织的血管中获取;上皮组织内有丰富的神经末梢,能感受各种刺激。

组织学与胚胎学复习重点组胚第一章组织学绪论1.组织学(histology):研究集体细微结构及其相关功能的科学。
2.HE染色:即苏木精、伊红染色法,苏木精染液呈碱性,使细胞核、粗面内质网、核糖体(嗜碱性)染成蓝紫色,伊红染料呈酸性,使线粒体、滑面内质网、溶酶体(嗜酸性)染成红色。
高尔基复合体呈中性,无着色。
标本制作:切片法和非切片法切片法:石蜡切片术(1)取材与固定:(2)脱水与包埋:(3)切片与染色:苏木精和伊红染色,简称HE染色苏木精特点:碱性,使细胞核内染色质以及细胞质内核糖体等染成紫蓝色;伊红特点:酸性,使细胞质以及细胞外基质中成分染成粉红色嗜碱性:细胞核、粗面内质网、游离核糖体嗜酸性:细胞质基质、溶酶体、线粒体嗜铬性:经重铬酸盐处理后呈棕褐色亲银性:硝酸银处理后呈黑色嗜银性:若经硝酸银处理后,尚需还原剂才显色异染性:肥大细胞中颗粒经甲苯胺蓝等碱性染料染色后呈紫红色(4)封片:非切片法:涂片、铺片、磨片第二章上皮组织1.上皮组织结构特点:①细胞多,排列紧密,细胞外基质少②细胞具有极性,有游离面和基底面③上皮内无血管,神经末梢丰富④细胞间常有特化的细胞连接2.被覆上皮①单层扁平上皮由一层很薄的扁平细胞构成,互相嵌合内皮:心脏、血管及淋巴管腔面(循环系统)薄,利于交换;光滑,利于血液流动间皮:胸膜、腹膜及心包膜腔面(体腔)湿润光滑,减少器官间的摩擦②单层立方上皮位于甲状腺滤泡及肾小管上皮由一层近似立方形细胞构成,核圆居中,具有分泌和吸收功能③单层柱状上皮位于胃、肠道和子宫、胆囊核椭圆,有吸收或分泌功能④假复层纤毛柱状上皮位于呼吸道由柱状细胞、杯状细胞组成,所有细胞的基底面均附着在基膜上,核的位置高低不齐地排列在不同的水平面上,实为单层,具有保护功能⑤复层扁平上皮未角化:食管、肛门、口腔、阴道角化:皮肤浅层细胞扁平,基底层细胞具有旺盛的分裂增殖能力,不断补充表层脱落的细胞,具有很强的保护作用⑥变移上皮位于肾盏、肾盂、输尿管、膀胱管道细胞的形态和层数可随所在器官的收缩和扩张状态不同而改变3.微绒毛:游离面的细胞膜和细胞质共同伸出的细小指状突起LM:纹状缘、刷状缘(由密集的微绒毛整齐排列而成)(密集可见,EM下才能清晰辨认)EM:外包细胞膜,内为细胞质,含有微丝功能:微绒毛显著扩大了细胞游离面的表面积,有利于细胞的吸收功能4.纤毛:游离面伸出突起,粗且长,能节律性定向摆动LM下可辨认,EM:外包细胞膜,细胞质内含纵行排列的微管(中央2条单独的微管,周围9组二联微管)功能:分布于呼吸道、输卵管等处,纤毛规律地摆动,可将灰尘、细菌等推向咽部排出第三章固有结缔组织1.间充质:由间充质细胞和无定形的液态基质组成,分化程度低,有很强的增殖分化能力2.疏松结缔组织细胞种类多,细胞数量少,纤维数量少,排列疏松,分布非常广泛作用:支持、连接、营养、修复、防御、保护①成纤维细胞:扁平,有多个突起,呈弱嗜碱性,核大,着色浅,核仁明显,丰富的RER、游离核糖体和发达的高尔基复合体功能:产生基质和纤维②巨噬细胞:形态不规则,呈嗜酸性,内含溶酶体、吞噬体、吞饮小泡功能:有很强的吞噬功能;趋化性;抗原呈递作用;分泌生物活性物质(溶菌酶、补体、白细胞介素I)③浆细胞:圆形或卵圆形,胞质丰富,嗜碱性,核旁有一浅染区,核偏位,似车轮,丰富的RER、游离核糖体、高尔基复合体,由B淋巴细胞接受抗原刺激转化而来功能:产生抗体,参与机体体液免疫反应④肥大细胞:沿血管成群分布,含异染性颗粒,有特殊染色功能:内含白三烯、组胺(与过敏反应有关)、肝素(具有抗凝血作用)3.蛋白多糖:由蛋白质和糖胺多糖结合而成。

1.石蜡切片的厚度一般是5-10um2.上皮的分类依据是上皮的功能3.被覆上皮的分类依据是细胞的层数和形态4.复层扁平上皮细胞之间最发达的细胞连接是桥粒5.胃的上皮组织属于单层柱状上皮无杯状细胞6.甲状腺滤泡壁的单层立方上皮是腺上皮7.微绒毛内纵形排列的结构是微丝8.纤毛的内部有微管,光镜下可见,内有9+2微管,具有节律性定向摆动功能9.缝隙连接具有通讯功能,侧重于非连接功能10.杯状细胞是一种散在分布的单细胞腺体11.纹状缘和刷状缘都是由大量的微绒毛聚集所形成的12.构成基质蛋白多糖复合体的主干是透明质酸,癌细胞等可产生透明质酸酶破坏基质的分子筛13.产生组织液的部位是毛细血管动脉端14.与腱细胞构成肌腱的是胶原纤维束15.被醛复红染成紫色的是弹性纤维16.浆细胞胞质嗜碱性是由于粗面内质网发达17.可产生胶原纤维的细胞有:成纤维细胞,软骨细胞,血管壁平滑肌细胞,成骨细胞18.未分化的间充质细胞可分化成成纤维细胞,平滑肌细胞,血管内皮细胞19.明带仅由细肌丝构成,H带仅有粗肌丝。
1根细肌丝周围排列着3根粗肌丝,1根粗肌丝周围有6根细肌丝20.骨骼肌纤维的光镜结构特点是肌纤维呈细长圆柱形,多核,位于肌膜下方21.骨骼肌纤维的横纹成因是每条肌原纤维有明暗相间的横纹,这些横纹在肌纤维中排列在同一水平上22.横小管是肌膜向肌浆内凹陷形成的管状结构,其走向和肌纤维长轴垂直23.星形胶质细胞,位于中枢神经系统的灰质和白质内,胞质内有大量的胶质丝,主要起支持和分隔作用24.肌梭的主要功能是感受肌纤维的伸缩变化(感觉骨骼肌的压觉是错误的),只分布于骨骼肌,结缔组织被覆包裹几条细小肌纤维,感觉神经纤维的轴突进入其内包绕肌纤维25.突触的前膜和后膜的胞质面可见致密物质附着26.有髓神经纤维髓鞘的主要作用是绝缘和利于加快神经冲动的传导速度27.属于神经元释放的神经递质或神经调质的是:乙酰胆碱,去甲肾上腺素,神经肽,NO28.周围神经系统的无髓神经纤维,一个施万细胞可包含许多条轴突(F)29.中枢神经系统的有髓神经纤维,少突胶质细胞的多个突起末端可包裹多个轴突(T)30.一个运动神经元支配的骨骼肌细胞很多,而一骨骼肌细胞只接受一个轴突分支的支配31.虹膜基质为富含血管和色素细胞的疏松结缔组织32.睫状肌肌纤维有纵向,放射状和环形3种走向,睫状肌是平滑肌,睫状体包括睫状肌,基质和上皮33.分泌房水的是睫状体非色素上皮细胞34.脉络膜衬于巩膜内面,富含血管和色素细胞的疏松结缔组织,为血管膜的后2/3部分35.视细胞的膜盘是外节基部一侧的胞膜向胞质内凹陷形成36.外耳鼓膜3层,外层为复层扁平上皮,内层为单层扁平上皮37.眼的屈光装置包括晶状体,房水,玻璃体,角膜38.内耳的结构:膜迷路悬系在骨迷路内,形态和骨迷路相似,内外淋巴互不相通,感受器为膜迷路粘膜上皮的局部隆起39.位觉斑不同于壶腹嵴之处包括a.表面形态较平坦b.胞质膜含义碳酸钙结晶c.感受直线变速运动40.内耳螺旋器的毛细胞是感受听觉刺激的上皮细胞,包括内毛细胞和外毛细胞,均坐落于指细胞上,基部与耳蜗神经节的双极神经元的树突末端形成突触41.壶腹嵴的特点包括a.为膜半规管壶腹中的嵴状隆起b.壶腹帽为胶状的糖蛋白c.3个壶腹嵴互相垂直d.感受头部旋转变速运动42.位觉和听觉感受器都是由内耳膜迷路的上皮特化而成的,他们接受的刺激与内淋巴有关43.在人体中,内耳是唯一一个上皮中可以有血管的部位44.螺旋器:膜窝管基底膜上呈螺旋状走行的彭隆结构。

心血管系统的发生造血干细胞最早来源于卵黄囊胚外中胚层内的血岛关于原始心血管系统:为内皮性血管网左右对称最早形成2条心管是胚胎最早执行功能的系统心动脉端通过动脉囊与弓动脉相连心脏最早发生于胚盘头端、口咽膜前方的脏壁中胚层心管发生过程:围绕心腔腹侧的生心索形成一对并列的心管心管逐渐转到前肠腹侧、口咽膜尾端围心腔由心管的腹侧转到背侧左右心管逐渐融合成一条心管分隔左右心室的结构为左右心球嵴、心内膜垫、心底璧心肌组织关于心房分隔:原发隔与心内膜之间形成原发孔原发隔顶部吸收出现继发孔第五周末,心房顶部、原发隔右侧长处继发隔继发隔与心内膜垫之间留有卵圆孔,出生后逐渐关闭胚胎期血液可从右心房流入左心房胎儿出生后血循环变化的主要原因是胎盘血循环中断和肺开始呼吸胎儿出生后血循环变化为:脐静脉闭锁,右心房压力下降肺循环建立,左心房压力上升肺循环建立,动脉导管闭锁卵圆孔关闭静脉导管闭锁左、右心球嵴与心内膜垫三者融合异常可致室间隔膜部缺损出生后卵圆孔功能性关闭的原因是胎盘血循环中断和肺开始呼吸法洛四联症胚胎学发生原因:主动脉隔偏位卵圆孔未闭锁的原因:原发隔过度吸收、卵圆孔瓣上有穿孔、左、右心球嵴未融合胎儿血循环特点:肝内有静脉导管有动脉导管有脐动静脉有卵圆孔分流关于心外形建立:直的心管上膨大和缩窄相间出现心动脉端从腹侧向尾端移位心静脉端从背侧向头端移动原始心房从两端膨出直心管心室形成左心室分割原始心室的成分包括:心肌组织、心球嵴、心内膜垫组织分割房室管的结构是背、腹侧心内膜垫分隔原始心房的结构是原发隔、继发隔和心内膜垫分割心球动脉干的结构是心球嵴、动脉干嵴主动脉隔偏位导致主动脉或肺动脉狭窄主动脉隔未发生可致永存动脉干主动脉隔直行可导致主动脉错位出生后动脉导管管壁肌组织不能收缩可致动脉导管未闭心血管系统源自中胚层原始右心室源自心球近侧端永久右心房光滑部源自静脉窦右角永久左心房光滑部源自肺静脉及其属支泌尿系统和生殖系统的发生泌尿和生殖系统的主要器官共同起源于间介中胚层来自于间介中胚层的是:生肾索、尿生殖嵴,中肾嵴、生殖腺嵴关于中肾发生:中肾小管发生于生肾索由中肾小管和中肾管构成肾小囊和毛细血管共同构成肾小体中肾管由前肾管演化而来关于后肾发生:生后肾原基源自尾端生肾索集合小管、肾盏、肾盂均来自于输尿管芽输尿管芽起自中肾管尾端近泄殖腔处肾小管来自生后肾原基输尿管分化来的结构为集合小管、肾盏、肾盂、输尿管生肾后原基分化形成肾小管膀胱和尿道主要由尿生殖窦分化而来脐尿瘘由脐尿管未闭锁导致原始生殖细胞源自卵黄囊的胚外内胚层性腺向睾丸分化的决定性因素是睾丸决定因子有关睾丸发生:初级性索演化成生精小管生精小管的支持细胞由初级性索演化成而来生精小管之间的间充质分化为睾丸间质和白膜睾丸在引带作用下沿腹股沟逐渐下降至阴囊内有关卵巢发生:原始卵泡由次级性索断裂形成初级性索退化,被血管和基质取代形成卵巢髓质卵泡细胞由次级性索细胞分化而来卵原细胞有原始生殖细胞分化而来由中肾管演化而来:附睾管、射精管、输精管、精囊腺中肾旁管分化为子宫、输卵管、阴道穹窿部、输卵管伞端性未分化期生殖管道向男性分化需要雄激素和抗中肾旁管激素来自内胚层的是大部分膀胱和尿道成体由中肾演化而来的结构是输精管和射精管肾、输尿管和睾丸支持细胞来自间介中胚层后肾形成永久性肾肾小管远端和集合小管未接通引起多囊肾脐尿管未闭锁引起脐尿瘘中肾旁管下段未合并引起双子宫男胚的靶细胞缺乏雄激素受体引起睾丸女性化综合征消化系统和呼吸系统的发生关于原始消化管:头端有口咽膜封闭,尾端有泄殖腔膜封闭膜面卵黄囊相通可分化为消化和呼吸系统的主要器官是内胚层卷入胚体内形成内胚层可分化为:食管和胃上皮、气管和肺泡上皮、胸腺上皮、肝细胞和胰岛细胞由前肠分化的结构:十二指肠上端上皮、胆囊上皮、甲状腺滤泡上皮、咽鼓管上皮第三对咽囊背侧份形成下一对甲状旁腺中肠袢由脐腔退回腹腔时逆时针旋转180度胚胎生理性脐疝期间,中肠袢逆时针旋转90度由后肠分化的结构是肛管上段、膀胱、尿道、直肠肝脏和胆囊的原基是肝憩室关于泄殖腔:是后肠末端的膨大部腹侧与尿囊相通可分化为膀胱和尿道大部可分化为直肠和肛管上端胰腺的原基是背胰芽与腹胰芽喉以下呼吸系统的原基是喉咽管憩室气管食隔发育不良致气管食管瘘关于甲状腺的发生:原基来自内胚层甲状舌管为一盲管舌盲孔为甲状舌管起始处残留的浅凹人胚发育第13周,甲状腺开始分泌甲状腺激素新生儿啼哭时,脐部常渗出一些臭味粘稠物,最有可能患脐粪瘘婴儿因呼吸困难而去世最有可能时肺泡II型上皮细胞分化不良造成的咽鼓管来源于第一对咽囊腭扁桃体上皮来源于第二对咽囊胸腺上皮细胞来源于第三对咽囊上一对甲状旁腺来源于第四对咽囊肝和胰的原基来自于前肠气管和肺的上皮来自于前肠咽囊来自于前肠盲肠的原基来自中肠颜面、颈和四肢的发生面斜裂是由于上颌隆起与同侧外侧鼻隆起未融合人胚第四周的颜面包括:上颌隆起、下颌隆起、口凹、额鼻隆起第一对鳃弓参与颜面形成人胚头部两侧之间的间充质增生形成鳃弓相邻鳃弓之间的凹陷为鳃沟原始咽侧面内胚层之间向外膨出形成咽囊相对应的咽囊与鳃沟之间的结构为鳃膜人胚先后形成6对鳃弓,5对鳃沟鼻板是由额鼻隆起下缘两侧的外胚层增生形成的外侧腭突来自上颌隆起人中缺如、并伴有上颚前部缺损,究其原因可能是胚胎时期内侧鼻隆起发育异常造成的胚胎时期5-6周受到致畸因子作用导致唇部畸形上颌隆起与同侧鼻隆起愈合后形成上颌以及上侧唇外部左右内侧鼻隆起下缘向下延伸形成人中以及人唇正中部左右外侧鼻隆起发育形成鼻外侧壁和鼻翼额鼻隆起下缘两侧外胚层局部增厚形成鼻板胚胎学绪论与人体胚胎学总论致畸敏感期是指受精后3-8周内关于透明带反应:透明带结构发生了改变保证了单体受精卵细胞浅层皮质颗粒释放酶透明带所含精子受体分子变性Implantation植入的条件为:胚泡发育良好子宫内膜处于分泌期母体雌激素、孕激素的正常分泌胚泡适时达子宫腔关于blastocyst胚泡描述:约在受精后第四天完成内细胞群连于极端滋养层异位妊娠最常发生的部位是:输卵管关于卵黄囊:发生于受精后第2周由胚外内胚层和胚外中胚层组成其尾侧向蒂内延伸形成尿囊原始消化管形成后其中部与卵黄囊相通关于三胚层胚盘:呈椭圆形,头端大,尾端小口咽膜中不含中胚层由外胚层、中胚层和内胚层组成三胚层均源于上胚层细胞人胚卵黄囊的顶和羊膜腔的底形成二胚层胎盘诱导神经管形成的结构是:脊索神经管前孔未闭合可形成:无脑儿前置胎盘发生原因是由于胚泡植入在近子宫颈处原始生殖细胞来远于卵黄囊的胚外内胚层由受精卵发育而来的结构:羊膜、脐带、绒毛膜、卵黄囊有关原条的描述:由上胚层细胞增殖形成原结的细胞增殖迁移形成脊索胚内中胚层来自于原条原条所在一端为胚盘的尾端造血干细胞最早来源于卵黄囊的胚外中胚层脑和脊髓来源于外胚层Ectoderm原始消化管由内胚层卷入胚体形成卵巢来自于间介中胚层受精过程包括:顶体反应、透明带反应、精卵结合、雌、雄原核融合有关绒毛膜:初级绒毛膜干仅有合体滋养层和细胞滋养层组成绒毛干依次发育成为初级绒毛膜干、次级绒毛膜干和三级绒毛膜干从密绒毛膜参与胎盘的构成绒毛膜由滋养层与胚外中胚层共同组成肝动脉与脐静脉来自尿囊的胚外中胚层关于胎盘:由胎儿的丛密绒毛膜与母体的基蜕膜组成胎盘内有两套血液循环胎盘膜的构成:合体滋养层、绒毛内薄层结缔组织、细胞滋养层及基膜、绒毛内毛系血管基膜与内皮临床上用于诊断早期妊娠的激素是人绒毛促性腺激素胎儿出生时,脐带剪断后流出的血是胎儿的动、静脉血胚泡开始植入的时间相当于月经周期的20-21天人胚胎发育的桑葚胚以前阶段所含细胞具有发育成完整胚胎的潜能来自于内胚层的结构:食管、胃、十二指肠、肺妊娠期与乳腺发育无关的激素是垂体促甲状腺激素人绒毛促性腺激素是由合体滋养层细胞合成与分泌圆柱状胚体形成后胚胎位于羊膜腔受精的条件:输卵管顺畅、精子形态正常、镜子运动正常、精子数量正常正常情况下位于输卵管壶腹部的是受精卵植入子宫内膜的是胚泡人胚胎发育第二周形成的是二胚层胎盘由12~16个卵裂球构成的实心胚是桑葚胚第三周初在上胚层尾端纵行的细胞索是原条位于胚盘头端中轴线的细胞索是脊索口咽膜不包含的胚层是中胚层呼吸道上皮来源于内胚层眼与耳有关角膜:角膜有五层构成角膜上皮是复层扁平上皮角膜上皮基地面光滑角膜上皮神经末梢丰富角膜基质中胶原纤维平行成层排列有关血管膜:富含血管与色素由前向后分别由虹膜、睫状体和脉络膜组成关于视杆细胞:顶端膜盘可被色素上皮吞噬膜盘上镶嵌的是视紫红质缺乏感光物质会致夜盲关于视锥细胞:膜盘上镶嵌的物质是视色素缺乏感光物质会致色盲黄斑中央凹由色素细胞上皮和视锥细胞组成角膜透明的原因:角膜内无血管角膜上皮基地面平坦角膜基质中胶原纤维平行成层排列角膜基质中富含水分关于房水:产出和排除保持动态平衡可经瞳孔由后房流入前房回流受阻时,眼压升高,可致青光眼可来自血液渗透和非色素上皮细胞分泌关于睫状体:睫状肌收缩可致睫状小带松弛,晶状体变厚关于听弦:位于膜蜗管基底膜中声波传来可产生振动由胶原样细丝组成与内淋巴液与外淋巴液相邻关于膜蜗管:基底膜上有听觉感受器关于位觉斑:包括圆囊斑和球囊斑有支持细胞和毛细胞组成上皮顶部由胶质状耳石膜可感受直线运动及头部在静止状态时的位置关于壶腹嵴:可感受头部旋转运动开始和终止的刺激螺旋器的特点:位于膜蜗管基底膜上组成细胞间有内隧道毛细胞游离面有排列规则的静纤毛毛细胞是特化的上皮细胞位置感觉器产生的神经冲动经过前庭神经传入中枢螺旋器产生的神经冲动经过耳蜗神经传入中枢Muller缪勒氏细胞属于神经胶质细胞垂体细胞属于神经胶质细胞螺旋器毛细胞的纤毛溶解、消失、出现耳聋晶体透明度下降甚至浑浊,出现白内障出生后玻璃体导管还有血液通过,出现飞蚊症男性生殖系统有关睾丸的描述:实质由生精小管组成间质细胞位于生精上皮间的结缔组织内能够发育成精子的是:生精细胞婴幼儿时期男性生精上皮的组成:精原细胞和支持细胞关于精子的发生:光镜下生精小管内的次级精母细胞不宜观察到精子细胞染色质高度浓缩,构成精子头部精子细胞高尔基复合体形成精子的顶体中心粒发出轴丝,形成精子的鞭毛关于支持细胞:位于生精细胞之间相邻细胞侧面近基底部细胞膜可形成紧密链接可结合蛋白可吞噬消化残余体细胞侧面及游离缘镶嵌各级生精细胞血-睾屏障:生精小管基膜毛细血管内皮与基膜薄层结缔组织支持细胞侧面紧密连接关于附睾:分为头、体、尾三部分由输出小管和附睾管组成输出小管上皮由高柱状纤毛细胞和低柱状无纤毛细胞构成附睾管上皮为假复层柱状睾丸间质可分泌雄激素睾丸支持细胞分泌雄激素结合蛋白位于生精小管基膜上的是精原细胞可进行有丝分裂的是初级精母细胞可刺激间质细胞合成分泌雄激素的是促黄体激素LH可促进支持细胞合成雄激素结合蛋白的是促卵泡激素FSH使胚胎中期的中肾旁管退化的是中肾旁管抑制素女性生殖系统A型题①关于卵巢:表面被覆单层扁平或立方上皮皮质内含不同发育阶段的卵泡髓质为疏松结缔组织女子医生双侧卵巢共排卵约400~500个②原始卵泡的特点:中央为一个初级卵母细胞周围一层扁平细胞数量多位于皮质浅层③初级卵泡的特点:中央为一个初级卵母细胞卵泡周围有卵泡膜透明带立方或柱状的卵泡细胞④初级卵泡发育过程中,出现卵泡腔时称为次级卵泡⑤次级卵泡:出现卵泡腔,内含卵泡液出现卵丘与放射冠颗粒细胞不断增加卵泡膜分为内外两层,内层含膜细胞和毛细血管⑥卵泡发育:青春期开始在促性腺激素的作用下部分卵泡开始发育每个月经周期都有若干个原始卵泡生长发育卵泡发育经历原始卵泡、生长卵泡、成熟卵泡3个阶段每个经期通常只有一个卵泡发育成熟并排卵⑦初级卵母细胞第一次减数分裂完成于排卵前36~48h内⑧从卵巢排出的是次级卵母细胞⑨成熟卵细胞形成于受精时⑩关于黄体:是排卵后留在卵巢内的卵泡壁发育而成新鲜时呈黄色主要有颗粒黄体和膜黄体细胞构成退化后形成白体①①关于子宫底与体部内膜:由单层柱状上皮和下方固有层构成浅层功能层发生周期性脱落基底层可修复脱落的功能层螺旋动脉、基质细胞以及子宫腺随卵泡发育呈周期性变化卵巢排卵后子宫内膜进入分泌期①②关于透明带:位于卵母细胞和卵泡细胞之间富含糖蛋白嗜酸性在精卵识别及结合中发挥重要作用①③子宫内膜周期性变化无调节作用的激素是松弛素①④出生后女性卵巢中不存在卵原细胞①⑤月经周期的14~16天为受孕期B型题下丘脑分泌的是:促性腺激素释放激素直接刺激卵泡发育的是:促卵泡激素促进排卵和黄体形成的是:促黄体生成激素卵泡发育过程中分泌的是:雌激素生长卵泡中含有:初级卵母细胞排卵时排出的是:次级卵泡细胞生后卵巢中原始卵泡含有:初级卵母细胞与第二极体同时形成的是:成熟卵细胞泌尿系统A型题①直集合小管不存在于皮质迷路中②肾小球(血管球与肾小囊)Renal corpulscle位于皮质迷路与肾柱③肾小体血管球:是动脉毛细血管网;由一条入球微动脉形成内皮细胞呈负电荷入球微动脉较出球微动脉管径大,毛细血管内压大。

组织与胚胎学专业知识考试题库(含答案)一、单选题1.关于脾功能的描述,错误的是A、清除血液中的抗原B、清除衰老的红细胞C、有储血功能D、无造血潜能E、清除衰老的血小板参考答案:D2.疏松结缔组织中,称为嗜银纤维的是A、胶原纤维B、弹性纤维C、网状纤维D、胶原纤维束E、微原纤维参考答案:C3.关于肺的组织结构的描述,错误的是A、每一条小支气管的各级分支及其所属的肺泡构成一个肺小叶B、Ⅰ型肺泡上皮细胞参与构成肺泡壁C、肺实质由导气部和呼吸部构成D、呼吸部包括呼吸性细支气管、肺泡管、肺泡囊和肺泡E、Ⅱ型肺泡细胞可分泌表面活性物质参考答案:A4.关于小肠皱襞的描述,正确的是A、由粘膜和粘膜下层向肠腔形成的突起B、由粘膜上皮和固有层向肠腔形成的指状突起C、由粘膜上皮和固有层凹陷形成D、由粘膜上皮和粘膜肌层向肠腔形成的突起E、由粘膜和肌层向肠腔形成的突起参考答案:A5.分泌男性性激素的细胞是A、生精细胞B、初级精母细胞C、间质细胞D、精子细胞E、支持细胞参考答案:C6.卵巢的功能是A、产生卵泡B、分泌女性性激素C、受精的部位D、产生卵泡和分泌女性性激素E、产生生长激素参考答案:D7.肾小体的作用是A、重吸收B、浓缩尿液C、产生原尿D、Na+感受器E、分泌肾素参考答案:C8.下列不属于宫外孕的是A、输卵管壶腹部妊娠B、子宫颈妊娠C、腹腔妊娠D、卵巢妊娠E、输卵管峡部妊娠参考答案:B9.肺的呼吸部包括A、细支气管、肺泡管、肺泡囊、肺泡B、呼吸性细支气管、肺泡管、肺泡囊、肺泡C、终末细支气管、肺泡管、肺泡囊、肺泡D、细支气管、呼吸性细支气管、肺泡囊、肺泡E、终末细支气管、呼吸性细支气管、肺泡囊、肺泡参考答案:B10.气血屏障的结构组成是A、Ⅱ型肺泡上皮细胞与基膜、薄层结缔组织、毛细血管基膜与内皮B、肺泡表面液体层、Ⅰ型肺泡上皮细胞、薄层结缔组织C、肺泡表面液体层、Ⅰ型肺泡上皮细胞与基膜、薄层结缔组织、毛细血管基膜与内皮D、肺泡表面液体层、Ⅱ型肺泡上皮细胞与基膜、毛细血管基膜与内皮E、肺泡表面液体层、薄层结缔组织、毛细血管基膜与内皮参考答案:C11.放射冠是指A、紧靠透明带的一层柱状卵泡细胞B、紧靠卵泡腔的一层卵泡细胞C、紧靠透明带的一层立方形卵泡细胞D、卵泡膜内层的结缔组织细胞E、卵泡壁最外层的卵泡细胞参考答案:A12.有关肾上腺髓质的描述,错误的是A、位于肾上腺的中央部B、髓质主要由髓质细胞构成C、髓质细胞内含有嗜铬颗粒D、髓质细胞分泌肾上腺素和去甲肾上腺素E、髓质内有少量副交感神经节细胞参考答案:E13.构成肾小囊脏层的是A、内皮细胞B、足细胞C、基膜D、球旁细胞E、球外系膜细胞参考答案:B14.小肠肌层的平滑肌走形为A、内纵中环外斜B、内斜中环外纵C、内环外纵D、内纵外环E、内环外斜参考答案:C15.呆小症是由以下何种激素分泌不足所致A、甲状腺激素B、促甲状腺激素C、促甲状腺激素释放激素D、生长激素E、促性腺激素参考答案:A16.人月经周期一般为A、14天B、28天C、15天D、30天E、30或31天参考答案:B17.盐酸的主要作用是A、促进内因子吸收B、稀释毒物C、消化蛋白质D、激活胃蛋白酶原和杀菌E、消化淀粉参考答案:D18.心肌膜的心肌纤维排列是A、内纵中环外斜B、内斜中环外纵C、内环外纵D、内环中斜外纵E、内纵中斜外环参考答案:A19.一个肌节的组成是A、I带+A带B、1/2I带+1/2A带C、1/2A带+I带D、1/2A带+I带+1/2A带E、1/2I带+A带+1/2I带参考答案:E20.在疏松结缔组织中,较多较常见的细胞是A、脂肪细胞B、浆细胞C、肥大细胞D、成纤维细胞E、巨噬细胞参考答案:D21.外周阻力血管是指A、毛细血管B、大动脉C、中动脉D、小动脉E、主动脉参考答案:D22.线粒体的功能是A、合成核糖核酸B、提供能量C、合成蛋白质D、合成粘多糖和脂类E、分泌蛋白质参考答案:B23.膜黄体细胞与颗粒黄体细胞协同分泌A、松弛素B、孕激素C、雌激素D、黄体生成素E、松弛素和雌激素参考答案:C24.下列描述肌细胞形态结构的相关对应术语中,错误的是A、肌细胞—肌纤维B、肌浆网—粗面内质网C、暗带—A带D、肌细胞胞质—肌浆E、横小管—T小管参考答案:B25.分泌盐酸及内因子的细胞是A、主细胞B、壁细胞C、潘氏细胞D、杯状细胞E、柱状细胞参考答案:B26.消化管壁由内向外分A、粘膜、固有层、粘膜下层、外膜B、上皮、粘膜下层、肌层、外膜C、粘膜、固有层、肌层、外膜D、粘膜、粘膜下层、肌层、外膜E、上皮、固有层、粘膜下层、外膜参考答案:D27.心肌的特征性结构是A、肌原纤维B、肌浆C、肌膜D、闰盘E、肌节参考答案:D28.基本组织不含A、上皮组织B、结缔组织C、肌组织D、神经组织E、软骨组织参考答案:E29.有关内分泌腺的特点,错误的是A、腺细胞排列成团成索或围成滤泡B、有的滤泡与导管相连C、腺细胞的分泌物称激素D、激素作用于靶器官或靶细胞E、腺细胞间有丰富的毛细血管参考答案:B30.中膜中不含内弹性膜的血管是A、大动脉B、中动脉C、小动脉D、微动脉E、锁骨下动脉参考答案:D31.胃的上皮是A、单层柱状上皮B、单层立方上皮C、假复层纤毛柱状上皮D、复层扁平上皮E、单层扁平上皮参考答案:A32.次级卵泡中的卵细胞为A、卵原细胞B、初级卵母细胞C、次级卵母细胞D、成熟卵细胞E、卵子参考答案:B33.胃底腺主细胞分泌A、凝乳酶B、外因子C、胃蛋白酶原D、肾素E、盐酸参考答案:C34.甲状腺滤泡旁细胞可分泌A、甲状旁腺素B、降钙素C、高血糖素D、T3E、T4参考答案:B35.分布于甲状腺滤泡腔面的是A、内皮B、间皮C、单层立方上皮D、单层柱状上皮E、假复层纤毛柱状上皮参考答案:C36.致密斑的作用是A、分泌肾素B、分泌促红细胞生成素C、感受钾离子浓度的变化D、感受钠离子浓度的变化E、可升高血压参考答案:D37.主细胞的功能是A、分泌盐酸B、分泌内因子C、分泌胃蛋白酶D、分泌胃蛋白酶原E、分泌盐酸及内因子参考答案:D38.女性的生殖腺是A、子宫B、卵巢C、输卵管D、肾上腺E、下丘脑参考答案:B39.可分泌肾上腺素及去甲肾上腺素的是A、主细胞B、肾上腺髓质细胞C、嗜银细胞D、球状细胞E、交感神经节细胞参考答案:B40.吞咽时随着喉上下移动的器官是A、前列腺B、甲状腺C、胸腺D、泪腺E、胰腺参考答案:B41.关于近曲小管的描述,错误的是A、是重吸收的主要部位B、吸收原尿中全部的蛋白质、氨基酸、葡萄糖C、其管壁腔面形成刷状缘D、近曲小管管腔内有大量的微绒毛E、是离子交换的重要部位参考答案:E42.疏松结缔组织中,不含有下列哪种细胞A、脂肪细胞B、浆细胞C、肥大细胞D、单核细胞E、成纤维细胞参考答案:D43.以下哪种细胞不属于单核吞噬细胞系统A、肺巨噬细胞B、单核细胞C、巨噬细胞D、中性粒细胞E、肝巨噬细胞参考答案:D44.淋巴结皮质的主要组成是A、浅层皮质、弥散淋巴组织B、淋巴窦、浅层皮质C、浅层皮质、副皮质区、皮质淋巴窦D、淋巴索、淋巴窦、副皮质区E、淋巴索、淋巴窦参考答案:C45.骨胳肌纤维中调节肌浆中钙离子浓度的结构是A、肌浆网B、肌原纤维C、线粒体D、高尔基复合体E、粗面内质网参考答案:A46.下列不属于固有结缔组织的是A、疏松结缔组织B、致密结缔组织C、脂肪组织D、淋巴组织E、网状组织参考答案:D47.脾白髓中,动脉周围淋巴鞘的组成是A、中央动脉与弥散淋巴组织B、中央动脉与淋巴小结C、中央静脉与弥散淋巴组织D、中央静脉与淋巴小结E、淋巴小结参考答案:A48.以下关于血管的描述,错误的是A、毛细血管分连续性毛细血管、有孔毛细血管、血窦三种B、小动脉平滑肌痉挛可导致高血压病C、大动脉又称弹性动脉D、微循环是指从微动脉和毛细血管中的血液循环E、中动脉可调节进入各器官的血流量参考答案:D49.肝的基本结构单位是A、肝细胞B、肝板C、肝血窦D、肝小叶E、胆小管参考答案:D50.某患者支气管哮喘发作,主要是由于何处的平滑肌痉挛所致A、肺叶支气管B、小支气管C、细支气管及终末细支气管D、呼吸性细支气管E、肺泡参考答案:C51.透明软骨中所含的纤维是A、胶原纤维B、胶原原纤维C、弹性纤维D、网状纤维E、胶原纤维束参考答案:B52.构成胃粘膜屏障的是A、表面粘液细胞分泌的粘液B、表面粘液细胞间的紧密连接C、表面粘液细胞分泌的胃蛋白酶原D、表面粘液细胞间的紧密连接及中间连接E、表面粘液细胞分泌的粘液及细胞间的紧密连接参考答案:E53.肺的结构和功能单位是A、支气管树B、肺小叶C、肺泡D、肺泡隔E、肺泡孔参考答案:B54.以下关于消化系统结构的描述,错误的是A、胃底腺的壁细胞可分泌盐酸和内因子B、胃底腺的主细胞可分泌胃蛋白酶和凝乳酶C、消化管壁由内向外分粘膜、粘膜下层、肌层、外膜四层D、小肠绒毛中轴中含丰富的毛细血管、中央乳糜管和平滑肌细胞等结构E、小肠扩大吸收面积的结构是皱襞、肠绒毛、吸收细胞的微绒毛参考答案:B55.下列各部位的上皮组织,不属于被覆上皮的是A、心脏的内表面B、肠的内表面C、血管的内表面D、气管的内表面E、肝小叶参考答案:E56.关于红细胞的描述,错误的是A、红细胞内含血红蛋白B、血红蛋白参与运输O2和CO2C、血红蛋白与CO2的结合能力较强D、血液中红细胞数量最多E、红细胞膜上的ABO抗原决定ABO血型参考答案:C57.单层扁平上皮不分布在以下哪个部位A、胸膜B、腹膜C、心包D、血管内表面E、输尿管参考答案:E58.胃黏膜上皮的柱状细胞分泌A、胃蛋白酶原B、5-羟色胺C、粘液D、内因子E、H离子参考答案:C59.甲状腺滤泡上皮细胞分泌A、甲状旁腺素B、降钙素C、高血糖素D、甲状腺素E、肾素参考答案:D60.关于肺泡隔的描述,错误的是A、肺泡隔是肺泡之间的少量结缔组织B、肺泡隔内含丰富的毛细血管C、肺泡隔可见肺巨噬细胞D、肺泡隔内含少量弹性纤维E、肺泡隔内的弹性纤维可以对肺泡起牵拉作用参考答案:D61.蜂窝组织是指A、疏松结缔组织B、致密结缔组织C、脂肪组织D、淋巴组织E、网状组织参考答案:A62.心脏传导系统是指A、交感神经在心脏的分支B、副交感神经在心脏的分支C、特殊的心肌纤维D、结缔组织分化的纤维E、心肌纤维参考答案:C63.骨密质中不含A、内环骨板B、骨单位C、扁骨板D、外环骨板E、间骨板参考答案:C64.关于突触的描述,错误的是A、是神经元与神经元之间、或神经元与非神经元之间特化的细胞连接B、可分为电突触和化学性突触,人体多为电突触。

组织学与胚胎学重点总复习 Chapter 1 Epithelial Tissue (一)是非题 1.组织学( histology)是研究机体结构及其功能的科学. 2.PAS反应(过碘酸希夫反应)可显示组织细胞中的蛋白质. 3.原位杂交术是一种核酸分子杂交组织化学术,能测定细胞中核酸的有无及相对量. 4.透射电镜主要观察组织细胞的表面结构,扫描电镜主要观察细胞内的微细结构. 5.被覆上皮(covering epithelium)的分类是根据上皮细胞的形态和排列层次. 6.分布于胸膜、腹膜和心包膜表面的单层扁平上皮称为间皮(mesothelium). 7.膀胱的腔面为变移上皮,食管腔面为单层柱状上皮. 8.细胞衣是指构成细胞膜的糖蛋白和糖脂外伸的糖链. 9.桥粒(desmosome)可防止大分子物质从细胞外经细胞间隙进入组织内,常构成体内各种屏障的基础. 10.质膜内褶扩大细胞基底面的面积,有利于水分及电解质的转运. (二)名词解释 1.缝隙连接(gap junction): 1)又称通信连接,呈斑状. 2)电镜下,可见相邻两细胞间的细胞膜形成间断性的连接点。冷冻蚀刻术的研究证明,相邻细胞膜上有许多规则分布的柱状颗粒,称连接子(每个连接子由六个亚单位组成,中央围成小管). 3)功能是细胞间离子和小分于物质交换的通道,也利于冲动的传递. 2.基膜(basement membrane) 靠近结缔组织的一层称为网板,由网状纤维和基质组成(由成纤维细胞产生). 3)功能是起支持和连接作用,并具有半透膜性质,便于上皮组织与结缔组织的物质交换. 1)是介于上皮基底面与结缔组织之间的一层薄膜. 2)电镜下可分2层,靠近上皮细胞基底面的一层称为基板(为上皮细胞形成); (三)简答题 简述上皮组织的一般特征、分类和功能。 1.一般特征: ①细胞多,密集排列成层,细胞间质少 ②有极性(细胞的不同表面在结构何功能上具有明显的差别), 分为游离面、基底面和侧面 ③一般无血管 ④有丰富的神经末梢 2.分类:上皮组织分为被覆上皮、腺上皮和感觉上皮 3.功能:保护、吸收、分泌和排泄等

一.1、细胞、组织、器官之间的关系细胞是机体形态结构和功能的基本单位,是一切生物体新陈代谢,生长发育,繁殖分化的形态学基础。
(包括上皮组织,结缔组织,肌组织,神经组织)组织是由细胞群和细胞外基质构成。
器官是由四种组织以不同的数量和方式组合而成,具有特定的形态结构和生理功能。
2、光镜、电镜分辨率一般光学显微镜长度单位:0.2µm电子显微镜计量单位:0.1nm(纳米)3、石蜡切片术包括哪几步?取材、固定脱水、包埋切片、染色4、HE染色原理苏木精(Hematoxylin )碱性染料将嗜碱性物质(本身酸性)染成蓝色细胞核中的DNA、RNA细胞质中的核糖体伊红(Eosin)染色酸性染料将嗜酸性物质(本身碱性)染成红色细胞质膜性结构(线粒体、溶酶体、滑面内质网)和细胞间质5、涂片、铺片、磨片针对对象。
涂片:血细胞、分离细胞或脱落细胞可直接涂在玻片上铺片:疏松结缔组织撕成薄片铺在玻片上磨片:牙和骨等坚硬组织可磨成薄片二•1、试述被覆上皮组织的分类及其功能••2、简述上皮组织特点•1、大量细胞紧密排列,细胞间质少••2、细胞呈明显的极性分布,分游离面与基底面和侧面,基底面附着于基膜上••3、没有血管,但有丰富的神经末梢••3、单层柱状上皮形态结构功能•表面观:多边形或六角形•侧面观:细胞柱状,核长圆,近基底部•分布:胃,肠,胆囊,子宫的腔面•功能:吸收和分泌••名解:间皮、内皮、纹状缘、盖细胞、纤毛,微绒毛•间皮:分布在胸膜,腹膜和心包膜表面的单层扁平上皮称间皮,能减少器官间摩擦•纤毛:细胞游离面伸出的细长突起,具有定向节律性摆动的能力。
功能:定向推动颗粒物质及粘液•盖细胞:变移上皮的表层细胞可覆盖其深层几个细胞,故称盖细胞。
•纹状缘:由密集,排列整齐的微绒毛组成纹状缘•内皮:分布在心血管与淋巴管内表面单层扁平上皮•微绒毛:上皮细胞游离面的细胞膜和细胞质向腔面伸出的细小指状突起•1被覆上皮单层复层扁平上皮有利于物质交换,血液,淋巴液的流动,内脏的运动立方上皮吸收与分泌柱状上皮.吸收与分泌扁平上皮保护.柱状上皮保护变移上皮防止尿液侵蚀simplestratified假复层纤毛柱状上皮分泌粘液,消除异物,保护呼吸道。

组织胚胎学复习题一、选择题1 扫描电子显微镜主要用于观察A 细胞和组织的内部结构B 细胞和组织的表面结构C 细胞膜的内部结构D 细胞间质的结构E 细胞间连接的结构2 能被伊红染色的性质是A 中性B 嗜碱性C 嫌色性D 嗜酸性E 异染性3 能被苏木精染色的是A 线粒体B 滑面内质网C 核染色质D 溶酶体E 酶原颗粒4 下列哪种细胞器内含大量水解酶A 线粒体B 溶酶体C 高尔基复合体D 微体E 中心体5 细胞内分泌蛋白主要有哪种细胞器合成A 粗面内质网和游离核糖体B 粗面内质网和高尔基复合体C 游离核糖体D 滑面内质网E 高尔基复合体6 假复层纤毛柱状上皮分布于A 口腔B 外耳道C 胃D 气管E 子宫7 内皮分布于A 心包膜、胸膜、腹膜B 肺泡壁、肾小管细段、肾小囊壁层C 血管、淋巴管、心脏的内面D 肾小囊脏层E 体表8 关于上皮组织的特点以下哪项不正确A 细胞排列密集,细胞间质少B 细胞排列和结构有极性C 所有细胞基部均附着于基膜上D 细胞游离面有不同的特殊结构E 大都无血管,有神经末梢9 光镜下所见的纹状缘和刷状缘,电镜下是:A 微管B 微丝C 纤毛D 微绒毛E 张力丝10在电子显微镜下观察,小肠柱状上皮细胞游离缘的指状突起是A 纤毛B 绒毛C 伪足D 微绒毛E 纹状缘11 下列哪一种不属于细胞侧面的连接结构?A 桥粒B 中间连接C 紧密连接D 缝隙连接E 半桥粒12 巨噬细胞来源于血液中的A 间充质细胞B 单核细胞C 网状细胞D 内皮细胞E 中性粒细胞13 胞质中含异染性颗粒的细胞是A 巨噬细胞B 成纤维细胞C 浆细胞D 肥大细胞E 嗜酸性粒细胞14 成纤维细胞最基本的结构特点是A 胞质嗜酸性B 发达的粗面内质网C 细胞椭圆形D 核偏位E 大量的溶酶体15 巨噬细胞最主要的结构特点是A 形状不规则B 胞质嗜酸性C 胞核染色深D 大量各级溶酶体E 微丝及微管16 肥大细胞的主要功能是A 吞噬异物B 产生抗体C 产生基质D 参与过敏反应E 以上都不是17 具有吞噬细菌、异物及衰老细胞作用的细胞为A T淋巴细胞B 巨噬细胞C B淋巴细胞D 红细胞E 血小板18 产生抗体的细胞是A 成纤维细胞B 巨噬细胞C 浆细胞D 中性粒细胞E 肥大细胞19 分布于真皮的结缔组织A 主要由规则致密结缔组织B 主要由不规则致密结缔组织C 由疏松较细的胶原纤维组成D 由密集的弹性纤维组成E 细胞平行排列在纤维之间20 结缔组织中产生弹性纤维的细胞是A 肥大细胞B 浆细胞C 巨噬细胞D 成纤维细胞E 间充质细胞21 对破骨细胞的描述哪一项是错误的A 是一种多核巨细胞B 紧贴骨质一侧有皱褶缘C 胞质呈嗜酸性D 胞质中溶酶体较少E 来源于单核细胞22 弹性软骨和透明软骨结构的主要区别是A 纤维类型不同B 纤维数量和排列不同C 基质成分不同D 软骨细胞分布不同E 软骨膜不同23 骨原细胞分布于A 骨外膜B 骨内膜C 骨板之间D 骨外膜和骨板之间E 骨外膜和骨内膜24 骨板的组成是A 平行排列的细胞B 平行排列的细胞和骨盐C 交叉排列的胶原纤维和骨盐D 平行排列的胶原纤维和骨盐E 交叉排列的胶原纤维和细胞25 长骨的间骨板位于A 外环骨板内B 骨单位内C 骨单位之间D 内环骨板内E 骨膜下26 血小板的结构特点是A 双凸圆盘状B 双凹圆盘状C 球状D 扁平状E 以上都不对27 红细胞的形态是A 双凸圆盘状B 双凹圆盘状C 球状D 扁平状E 以上都不对28 区别有粒白细胞和无粒白细胞主要依据是A 细胞大小B 细胞核形态C 有无嗜天青颗粒D 有无特殊颗粒E 有无吞噬功能29 正常人血液中数量最多和最少的白细胞分别是A 中性粒细胞和单核细胞B 淋巴细胞和嗜碱性粒细胞C 中性粒细胞和嗜酸性粒细胞D 中性粒细胞和嗜碱性粒细胞E 淋巴细胞和单核细胞30 吞噬衰老红细胞能力最强的细胞是A 单核细胞B 中性粒细胞C 网状细胞D 巨噬细胞E 淋巴细胞31 正常成年人红细胞的产生部位是A 淋巴结B 脾C 淋巴组织D 肝E 红骨髓32 骨骼肌细胞的细胞膜凹入细胞内部,形成A 横小管B 肌浆网C Z膜D 终池E M膜33 骨骼肌纤维有A 一个长杆状核位于中央B 多个椭圆形核位于中央C 一个椭圆形核位于肌膜下方D 多个椭圆形核位于肌膜下方E 一个螺旋形核位于中央34 在骨骼肌纤维中纵小管与横小管分别为A 粗面内质网、终池及滑面内质网形成的肌浆网B 滑面内质网形成的肌浆网及肌膜凹陷C 粗面内质网、终池及肌膜凹陷D 肌膜凹陷及滑面内质网形成的肌浆网E 以上都不是35 电镜观察骨骼肌纤维,只有粗肌丝而无细肌丝的是A 暗带B H带C 明带D 明带和H带E 以上都不对36 骨骼肌纤维的Z线位于肌原纤维的A H带内B 暗带中央C 明带中央D 明暗带交界处E M膜36 横纹肌纤维内的Ca2+贮存在A 肌浆内B 肌浆网内C 原肌球蛋白上D 横小管内E 肌原蛋白上37 心肌细胞彼此相连形成功能整体是靠A T小管B 肌浆网C 闰盘D 肌丝E 二联体38 神经元胞体是细胞的营养中心,这主要是由于胞体内富含A 神经丝B 微丝C 微管D 高尔基复合体E 粗面内质网和游离核糖体39 神经元尼氏体分布在A 树突和胞体内B 轴突和胞体内C 轴突和树突内D 仅在胞体内E 整个神经元内40 化学性突触的突触前部内与信息传递直接相关的结构是A 线粒体B 微管C 神经丝D 微丝E 突触小泡41 具有吞噬功能的神经胶质细胞是A 少突胶质细胞B 星形胶质细胞C 小胶质细胞D 施万细胞E 卫星细胞42 细胞间具有缝隙连接的是A 骨骼肌纤维B 破骨细胞C 成纤维细胞D 心肌纤维E 浆细胞43 中枢神经系统内髓鞘是由()形成的A 星形胶质细胞B 少突胶质细胞C 小胶质细胞D 施万细胞E 卫星细胞44 周围神经系统中,髓鞘由()形成A 星形胶质细胞B 少突胶质细胞C 小胶质细胞D 施万细胞E 卫星细胞45 有髓神经纤维无髓鞘的部位是A 节间体B 施万细胞C 郎飞结(神经纤维节)D 髓鞘切迹E 轴膜46 Nissl小体的组成是A 高尔基复合体B 溶酶体C 滑面内质网D 粗面内质网及游离核糖体E 神经丝及微管47 轴突与树突结构的主要区别是A 神经微管B 神经丝C 线粒体D 粗面内质网E 滑面内质网48 每个神经元具有A 一个轴突及一个树突B 多个轴突及一个树突C 多个轴突及多个树突D 一个轴突及一个或多个树突E 以上都不是49 神经元的长突起和包绕它的神经胶质细胞构成A 神经B 神经纤维C 神经束D 神经原纤维E 以上都不是50 神经组织中具有明显吞噬功能的细胞为A 星形胶质细胞B 神经膜(施万)细胞C 少突胶质细胞D 小胶质细胞E 蒲肯野氏细胞51 神经元传导神经冲动是通过()传导A 轴膜B 神经递质C 神经丝D 微丝E 微管52 电镜下,化学突触最主要的标志是A 突触前膜B 突触后膜C 突触间隙D 突触小泡E 多泡体53 电突触的基本结构是A 紧密连接B 中间连接C 缝隙连接D 桥粒E 半桥粒54 血-脑屏障位于A 神经元之间B 神经元与肌纤维间C 血液与神经元之间D 在中枢神经系统内血液和神经组织之间E 以上都不是55 构成血-脑屏障的电镜结构是A 内皮、基膜和结缔组织B 连续毛细血管内皮、完整基膜和胶质膜C 有孔内皮、基膜和胶质膜D 连续性毛细血管内皮、基膜和被膜E 连续性毛细血管内皮、不完整基膜和胶质膜.56 连续毛细血管内皮细胞间最主要的连接方式是A 紧密连接B 中间连接C 突触D 缝隙连接E 相嵌连接57 连续毛细血管最常见于A 胸腺皮质B 小肠粘膜C 胰岛D 肾小球E 以上均不是58 浦肯野氏纤维主要位于A 心内皮下层B 心内膜下层C 心肌膜D 心外膜E 以上均不是59 有孔毛细血管存在的器官是A 骨骼肌B 肾血管球C 肺泡D 大脑皮质E 胸腺60 血窦存在于A 淋巴结B 肝脏C 胸腺D 大脑皮质E 骨骼肌61 毛细血管的结构是A 内皮以及内皮外有网状纤维缠绕B 内皮和周细胞C 内皮和基膜D 内皮、基膜和周细胞E 内皮和结缔组织62 血窦不存在于下列哪个器官中?A 淋巴结B 脾脏C 肝脏D 骨髓E 肾上腺63 有孔毛细血管与连续毛细血管的主要区别A 内皮细胞为连续的B 胞质薄,内皮上有许多孔C 胞质内含吞饮小泡少D 基膜薄而连续E 内皮外周细胞少64 血管壁的一般结构分为A 内皮、中膜、外膜B 内皮、内弹性膜、外膜C 内膜、中膜、外膜D 内膜、中膜、外弹性膜E 内弹性膜、中膜、外膜65 中动脉能调节器官血量的主要结构基础是A 中膜大量弹性纤维B 外膜比较厚C 中膜有丰富的平滑肌D 内皮表面光滑E 内、外弹性膜发达66 大动脉的主要结构特点是A 中膜比外膜厚B 中膜含基质C 中膜有平滑肌D 中膜有大量弹性膜E 内皮下层发达67 脾内具有A 有孔毛细血管B 连续毛细血管C 血窦D 淋巴窦E 毛细淋巴管68 心血管系统各段管壁共有的成分是A 内皮B 内弹性膜C 平滑肌D 外膜细胞E 外弹性膜67 下列哪种结构不属于心传导系统A 窦房结B 房室结C 房室束D 心上神经E 房室束左右分支68 血管内皮细胞胞质内吞饮小泡的主要作用是A 分泌产物B 贮存物质C 传递信息D 物质转运E 质膜储备69 与大动脉功能密切相关的结构成分是A 内弹性膜B 外弹性膜C 中膜的弹性膜D 平滑肌E 胶原纤维70 毛细血管可分为:A 连续毛细血管、有孔毛细血管、真毛细血管B 连续毛细血管、血窦、真毛细血管C 窦状毛细血管、真毛细血管、直接通路D 连续毛细血管、有孔毛细血管、血窦E 连续毛细血管、真毛细血管、直接通路71 淋巴小结的生发中心最主要的细胞是A 成纤维细胞B 巨噬细胞C T淋巴细胞D B淋巴细胞E 以上都不是72 淋巴结毛细血管后微静脉位于A 淋巴小结B 副皮质区C 髓索D 小梁73 当新生小鼠摘除胸腺后,淋巴结发生的明显变化为A 淋巴小结消失B 副皮质区萎缩C 髓索细而不发达D 淋巴窦变窄E 以上均不是74 淋巴结副皮质区毛细血管后微静脉的内皮为A 立方或柱状B 扁平形C 星形D 长杆状E 以上均不是75 造血干细胞发育成T淋巴细胞的主要器官是A 淋巴结B 脾C 胸腺D 扁桃体E 骨髓76 滤过血液的最主要器官是A 脾脏B 淋巴结C 胸腺D 肝脏E 以上都不是77 淋巴细胞出入白髓和红髓的最主要部位是A 脾小体(淋巴小结)B 动脉周围淋巴鞘C 边缘区D 脾窦E 脾索78 T淋巴细胞在脾内分布的最主要部位是A 脾小结B 动脉周围淋巴鞘C 边缘区D 脾索E 以上都不是79 B淋巴细胞A 参与细胞免疫B 参与体液免疫C 参与加工、传递抗原D 参与自然杀伤E 参与依赖抗体杀伤80 抗原呈递细胞存在于A 结缔组织和淋巴小结B 淋巴小结和弥散淋巴组织C 弥散淋巴组织和表皮D 表皮和肠上皮E 以上均对81 脾的功能包括:A 造血B 储血C 滤血D 免疫应答E 以上均对82 脾滤血的主要部位是A 脾窦B 脾小体C 脾索D 动脉周围淋巴鞘E 以上均不是83 脾内首先接触抗原引起免疫应答的重要结构是A 动脉周围淋巴鞘B 脾小结C 边缘区D 脾索E 脾窦84 淋巴结内的T淋巴细胞主要分布在A 浅层皮质B 深皮质C 髓索D 淋巴窦E 皮质与髓质交界处85 淋巴结内发生细胞免疫应答时,结构明显增大的是A 浅层皮质B 深皮质C 髓索D 皮质淋巴窦E 髓质淋巴窦86组成脾白髓的结构是A 动脉周围淋巴鞘和脾小体B 脾小体和脾索C 脾索和脾窦D 脾索和动脉周围淋巴鞘E 边缘区和脾索87 脾的胸腺依赖区是A 脾小体B 动脉周围淋巴鞘C 白髓D 脾索E 边缘区88 B淋巴细胞在脾内分布的最主要部位是A 脾索B 边缘区C 脾小体生发中心D 脾窦E 动脉周围淋巴鞘89 不属于单核吞噬细胞系统的细胞是A 巨噬细胞B 单核细胞C 小胶质细胞D 尘细胞E 中性粒细胞90 关于脾的功能以下哪一点是错误的A 清除血液中的抗原B 清除衰老的红细胞C 有一定的储血功能D 被膜和小梁的平滑肌收缩可调节脾内血流量E 无造血干细胞,故无造血潜能91 淋巴结内发生体液免疫应答的主要变化是A 深皮质增大B 髓质增大C 初级淋巴小结增多增大D 次级淋巴小结增多增大E 淋巴窦增大92 脾内发生细胞免疫应答的主要变化是A 脾索增大B 脾小体增多增大C 动脉周围淋巴鞘增厚D 边缘区增大E 脾血窦充血93 以下哪种细胞属于单核吞噬细胞系统?A 中性粒细胞B 嗜酸粒细胞C 肥大细胞D 浆细胞E 小胶质细胞94 组成表皮的两类细胞是A、角质细胞和黑素细胞B、角质形成细胞和梅克尔细胞C、郎格罕细胞和角质细胞D、角质形成细胞与非角质形成细胞E、黑素细胞和角质形成细胞95 表皮内具有增殖能力的部分是A、基底层B、棘细胞层C、颗粒层D、角化层E、以上都不是96 构成皮肤真皮层最主要的纤维成分为A、肌原纤维B、弹性纤维C、胶原纤维D、神经纤维E、神经原纤维97 决定皮肤颜色的重要因素是A、角化层厚度B、颗粒层厚度C、黑素细胞多少D、黑素颗粒含量多少及分布E、以上都不是98 毛发的生长点为A、上皮性毛囊B、结缔组织性毛囊C、毛母质D、毛乳头E、以上都不是99 触觉小体位于A、表皮B、真皮乳头层C、真皮网状层D、皮下组织E、以上都不是100 产生黑素的细胞是A、基底层细胞B、棘层细胞C、垂体嗜碱性细胞D、郎格汉斯细胞E、以上都不是101、郎格汉斯细胞的特性是A、由单核细胞演变而来B、细胞可传递抗原给淋巴细胞C、数量随着年龄变化D、在排斥移植的异体组织中起重要作用E、以上均对102、真皮乳头层的特点之一是A、纤维粗大,毛细血管少B、纤维粗大,毛细血管丰富C、纤维细密,毛细血管丰富D、纤维细密,毛细血管少E、纤维细密,富于静脉丛103 皮下注射是将药剂注射在A、真皮乳头层内B、真皮网状层内C、真皮和皮下组织内D、皮下组织内E、肌组织内104 小肠吸收细胞游离面有A 纤毛B 微绒毛C 绒毛D 鞭毛E 以上均无105 回肠与空肠的主要区别之一是A 固有层中有孤立淋巴小结B 固有层中有集合淋巴小结C 固有层中有弥散淋巴组织D 上皮内杯状细胞多E 上皮细胞微绒毛多106 单层柱状上皮中有柱状细胞而无杯状细胞的器官是A 空肠B 十二指肠C 胃底D 结肠E 阑尾107 消化管上皮中杯状细胞最多的是A 空肠B 十二指肠C 大肠D 回肠E 胃幽门108 胃底腺壁细胞除分泌盐酸外,还可分泌A 粘液B 胃蛋白酶C 内因子D 维生素B12E 以上都不是109 胃分泌胃蛋白酶原的细胞是A 主细胞B 壁细胞C 颈粘液细胞D 内分泌细胞E 未分化细胞100 潘氏细胞位于A 十二指肠腺B 食管腺C 胃底腺D 小肠腺底部E 粘膜下层101 有间皮覆盖结缔组织的结构称为A 粘膜B 固有膜C 内膜D 浆膜E 以上都不是102 能选择性地摄取肠腔内抗原的细胞是A 柱状上皮细胞B 杯状细胞C 巨噬细胞D 潘氏细胞E 微皱褶细胞(M细胞)103 纯浆液腺是A 食管腺B 气管腺C 胰的外分泌部D 十二指肠腺E 颌下腺104 正常情况下,具有大量杯状细胞的腺体是A 小肠腺B 食管腺C 胃底腺D 结肠腺E 以上都不是105 肠壁内合成和分泌免疫球蛋白(Ig)的细胞是A 柱状细胞B 浆细胞C 淋巴细胞D 微皱褶细胞E 以上都不是106 空肠的外膜是由()组成A 粘膜B 被膜C 纤维膜D 浆膜E 以上都不是107 小肠不具有()结构A 纤毛B 小肠腺C 淋巴组织D 环形皱襞E 绒毛108 属于粘液腺的是A 十二指肠腺B 胃底腺C 颌下腺D 胰腺外分泌部E 以上都不是109 小肠与大肠的主要区别点是A 绒毛B 肌层C 浆膜D 杯状细胞E 淋巴组织110 下述哪项不是肝巨噬细胞(Kupffer cell)的功能?A 清除血液中的异物B 吞噬破坏衰老的红细胞C 参与免疫应答D 形成脂褐素E 监视、抑制和杀伤体内的肿瘤细胞111 小肠绒毛不具备下列哪一结构?A 单层柱状上皮B 杯状细胞C 中央乳糜管D 平滑肌E 粘膜下层112 正常情况下,胃底腺不具有A 主细胞B 壁细胞C 内分泌细胞D 杯状细胞E 颈粘液细胞113 存在于消化管固有层内的腺体有A 食管腺,贲门腺,胃底腺,肠腺B 食管腺,幽门腺,胃底腺,肠腺C 食管腺,十二指肠腺,胃底腺D 胃底腺,贲门腺,幽门腺,肠腺E 十二指肠腺,肠腺114 组成胃底腺的细胞有A 主细胞,壁细胞,颈粘液细胞,杯状细胞B 主细胞,壁细胞,颈粘液细胞,潘氏细胞C 主细胞,壁细胞,颈粘液细胞,内分泌细胞D 主细胞,壁细胞,内分泌细胞,杯状细胞E 主细胞,壁细胞,内分泌细胞,潘氏细胞115 关于胃底腺主细胞的描述,何项错误?A 多位于胃底腺的体部和底部B 胞质嗜碱性C 胞质顶部有酶原颗粒D 细胞基部胞质内滑面内质网丰富,排列密集E 分泌胃蛋白酶原116 胃底腺的主要功能是A 壁细胞分泌盐酸,主细胞分泌胃蛋白酶原和内因子B 壁细胞分泌盐酸和内因子,主细胞分泌胃蛋白酶原C 壁细胞分泌胃蛋白酶,主细胞分泌盐酸D 壁细胞分泌粘液,主细胞分泌盐酸E 壁细胞分泌粘液和内因子,主细胞分泌盐酸117 壁细胞的盐酸合成部位在A 粗面内质网内B 滑面内质网内C 高尔基复合体内D 细胞内分泌小管内E 细胞基部的细胞膜上118 内因子与哪种维生素的吸收有关?A 维生素AB 维生素CC 维生素ED 维生素B2E 维生素B12119 小肠绒毛是A 粘膜上皮向肠腔伸出的指状突起B 粘膜下层及粘膜共同突向肠腔形成的突起C 上皮细胞表面的小突起D 粘膜上皮及固有层突向肠腔的小突起E 光镜下见到的纹状缘120 中央乳糜管存在于A 胃粘膜固有层B 结肠腺之间C 小肠绒毛内D 小肠粘膜下层E 小肠微绒毛内121 关于十二指肠的描述,哪一项正确?A 绒毛较细,呈指状B 粘膜下层内有集合淋巴小结C 固有层内无腺体D 粘膜下层有十二指肠腺E 肌层可分内斜、中环、外纵三层122 小肠绒毛固有层内与吸收有关的结构是A 中央乳糜管、连续毛细血管B 中央乳糜管、有孔毛细血管C 中央乳糜管、有孔毛细血管和环行散在的平滑肌D 中央乳糜管、有孔毛细血管和纵行散在的平滑肌纤维E 连续毛细血管网和散在的平滑肌纤维123 结肠带的形成是由于A 外膜局部增厚B 纵行肌局部增厚C 环行肌局部增厚D 粘膜下层局部增厚E 淋巴组织聚集124 分泌胰岛素的细胞是A D细胞B A细胞C S细胞D B细胞E I细胞125 与肝细胞合成胆汁有关的主要结构是A 粗面内质网B 滑面内质网C 溶酶体D 微体E 线粒体126 肝窦周间隙(Disse space)内有A 肝巨噬细胞B 单核细胞C 血细胞D 贮脂细胞E 以上都不是127 窦周间隙位于A 肝细胞与贮脂细胞之间B 肝细胞与肝巨噬细胞之间C 肝细胞与血窦内皮细胞之间D 肝细胞与肝细胞之间E 以上都不是128 肝小叶内不具有A 窦周间隙B 肝板C 血窦D 中央静脉E 中央动脉129 胰腺与腮腺的最主要区别是A 泡心细胞B 无分泌管C 闰管长D 胰岛E 以上都不是130 肝血窦内的血液来自于A 小叶间静脉B 小叶间动脉C 小叶下静脉D 中央静脉E 小叶间动脉和小叶间静脉131 与肝细胞的解毒功能有关的结构是A 高尔基复合体B 溶酶体C 粗面内质网D 滑面内质网E 以上都不是132 胆小管位于A 窦周间隙内B 相邻肝细胞之间C 门管区内D 肝小叶之间E 以上都不是133 胆小管管壁是A 单层扁平上皮B 单层柱状上皮C 复层扁平上皮D 相邻肝细胞膜凹陷而成E 以上都不是134 肝巨噬细胞位于A 肝小叶之间B 肝细胞索中C 肝血窦中D 窦周间隙E 胆小管中135 维生素A贮存在肝脏的()内A 肝细胞B 内皮细胞C 肝巨噬细胞D 贮脂细胞E 以上都不是136 肝细胞合成血浆蛋白的部位是A 高尔基复合体B 粗面内质网C 滑面内质网D 溶酶体E 微体137 下列哪一结构不在肝小叶内?A 肝板B 小叶下静脉C 胆小管D 肝血窦E 中央静脉138 肝门管区除含小叶间动脉、小叶间静脉尚有A 小叶间胆管B 小叶间胆管和结缔组织C 小淋巴管和结缔组织D 结缔组织E 以上都不是139 肝细胞产生的胆汁首先进入A 血窦B 中央静脉C 窦周间隙D 小叶间胆管E 胆小管140 胰腺外分泌部主要是A 浆液性腺B 粘液性腺C 混合腺D 小肠腺E 胃底腺141 分泌高血糖素的细胞是A G细胞B A细胞C S细胞D B细胞E D细胞142 胰岛D细胞分泌A 胰岛素B 高血糖素C 生长抑素D 促胰液素E 生长激素143 成人肝的肝板A 由几排肝细胞组成,无孔B 由几排肝细胞组成,有孔C 由单排肝细胞组成,无孔D 由单排肝细胞组成,有孔E 由几排肝细胞组成,有的有孔,有的无孔144 肝细胞表面有微绒毛的是A 胆小管面和肝细胞连接面B 肝细胞连接面和血窦面C 血窦面和胆小管面D 血窦面E 胆小管面145 关于肝小叶的结构以下哪一项是错误的A 肝板两侧的血窦是相互通连的B 胆小管位于肝板之间C 窦周隙与胆小管是互不通连的D 相邻肝板是相互吻合连接的E 中央静脉汇合为小叶下静脉146 肝血窦的结构特点是A 形状规则,内皮细胞间有间隙,无基膜B 形状规则,内皮细胞间有间隙,内皮无孔,无基膜C 形状不规则,内皮细胞间有间隙,基膜不完整D 形状不规则,内皮细胞间有间隙,内皮有孔,无基膜E 形状规则,内皮有孔,孔上有隔膜,基膜不完整147 贮脂细胞的特点之一是A 有产生纤维和基质的功能B 胞质的脂滴内贮存维生素DC 无增殖能力D HE切片中可辩认E 位于肝血窦内148 下列各项中,哪一项不属于胰腺结构?A 胰岛B 粘液性腺泡C 浆液性腺泡D 泡心细胞E 闰管149 肺导气部管壁内软骨片及腺体首先完全消失的部位是A 细支气管B 呼吸性细支气管C 小支气管D 段支气管E 肺泡管140 控制进入肺泡气流量的结构是A 肺内小支气管B 细支气管C 终末细支气管D 呼吸性细支气管E 肺泡管141 支气管树中,管壁不完整,具有肺泡开口的管为A 细支气管B 终末细支气管C 小支气管D 呼吸性细支气管E 以上均不是142 下述结构中与气体交换无关的是A Ⅰ型肺泡细胞B 毛细血管C 弹性纤维D 肺泡巨噬细胞E 肺泡孔143肺内含有嗜锇性板层小体的细胞是A 肺泡巨噬细胞B Ⅰ型肺泡细胞C Ⅱ型肺泡细胞D 肥大细胞E 以上都不是144 肺小叶不包括A 肺泡管B 呼吸性细支气管C 肺泡囊、肺泡D 小支气管E 细支气管145 呼吸性细支气管与细支气管的主要区别是A 单层柱状纤毛上皮B 无腺体C 有肺泡开口D 无软骨片E 有平滑肌146 气体由肺进入毛细血管必须经过A Ⅱ型肺泡细胞、结缔组织、毛细血管内皮细胞B Ⅰ型肺泡细胞及基膜、毛细血管内皮细胞C 表面活性物质、Ⅰ型肺泡细胞及其基膜、毛细血管内皮细胞及其基膜D Ⅱ型肺泡细胞及基膜、结缔组织、毛细血管内皮细胞E 以上都不是147 气-血屏障的结构不包括A Ⅰ型肺泡细胞B 上皮基膜C 内皮细胞D 内皮基膜E 巨噬细胞148 肺呼吸部不包括A 肺小支气管B 肺泡管C 肺泡D 肺泡囊E 呼吸性细支气管149 肺巨噬细胞吞噬灰尘后称A 内皮细胞。

组织学与胚胎学复习重点组胚第一章组织学绪论1.组织学(histology):研究集体细微结构及其相关功能的科学。
2.HE染色:即苏木精、伊红染色法,苏木精染液呈碱性,使细胞核、粗面内质网、核糖体(嗜碱性)染成蓝紫色,伊红染料呈酸性,使线粒体、滑面内质网、溶酶体(嗜酸性)染成红色。
高尔基复合体呈中性,无着色。
标本制作:切片法和非切片法切片法:石蜡切片术(1)取材与固定:(2)脱水与包埋:(3)切片与染色:苏木精和伊红染色,简称HE染色苏木精特点:碱性,使细胞核内染色质以及细胞质内核糖体等染成紫蓝色;伊红特点:酸性,使细胞质以及细胞外基质中成分染成粉红色嗜碱性:细胞核、粗面内质网、游离核糖体嗜酸性:细胞质基质、溶酶体、线粒体嗜铬性:经重铬酸盐处理后呈棕褐色亲银性:硝酸银处理后呈黑色嗜银性:若经硝酸银处理后,尚需还原剂才显色异染性:肥大细胞中颗粒经甲苯胺蓝等碱性染料染色后呈紫红色(4)封片:非切片法:涂片、铺片、磨片第二章上皮组织1.上皮组织结构特点:①细胞多,排列紧密,细胞外基质少②细胞具有极性,有游离面和基底面③上皮内无血管,神经末梢丰富④细胞间常有特化的细胞连接2.被覆上皮①单层扁平上皮由一层很薄的扁平细胞构成,互相嵌合内皮:心脏、血管及淋巴管腔面(循环系统)薄,利于交换;光滑,利于血液流动间皮:胸膜、腹膜及心包膜腔面(体腔)湿润光滑,减少器官间的摩擦②单层立方上皮位于甲状腺滤泡及肾小管上皮由一层近似立方形细胞构成,核圆居中,具有分泌和吸收功能③单层柱状上皮位于胃、肠道和子宫、胆囊核椭圆,有吸收或分泌功能④假复层纤毛柱状上皮位于呼吸道由柱状细胞、杯状细胞组成,所有细胞的基底面均附着在基膜上,核的位置高低不齐地排列在不同的水平面上,实为单层,具有保护功能⑤复层扁平上皮未角化:食管、肛门、口腔、阴道角化:皮肤浅层细胞扁平,基底层细胞具有旺盛的分裂增殖能力,不断补充表层脱落的细胞,具有很强的保护作用⑥变移上皮位于肾盏、肾盂、输尿管、膀胱管道细胞的形态和层数可随所在器官的收缩和扩张状态不同而改变3.微绒毛:游离面的细胞膜和细胞质共同伸出的细小指状突起LM:纹状缘、刷状缘(由密集的微绒毛整齐排列而成)(密集可见,EM下才能清晰辨认)EM:外包细胞膜,内为细胞质,含有微丝功能:微绒毛显著扩大了细胞游离面的表面积,有利于细胞的吸收功能4.纤毛:游离面伸出突起,粗且长,能节律性定向摆动LM下可辨认,EM:外包细胞膜,细胞质内含纵行排列的微管(中央2条单独的微管,周围9组二联微管)功能:分布于呼吸道、输卵管等处,纤毛规律地摆动,可将灰尘、细菌等推向咽部排出第三章固有结缔组织1.间充质:由间充质细胞和无定形的液态基质组成,分化程度低,有很强的增殖分化能力2.疏松结缔组织细胞种类多,细胞数量少,纤维数量少,排列疏松,分布非常广泛作用:支持、连接、营养、修复、防御、保护①成纤维细胞:扁平,有多个突起,呈弱嗜碱性,核大,着色浅,核仁明显,丰富的RER、游离核糖体和发达的高尔基复合体功能:产生基质和纤维②巨噬细胞:形态不规则,呈嗜酸性,内含溶酶体、吞噬体、吞饮小泡功能:有很强的吞噬功能;趋化性;抗原呈递作用;分泌生物活性物质(溶菌酶、补体、白细胞介素I)③浆细胞:圆形或卵圆形,胞质丰富,嗜碱性,核旁有一浅染区,核偏位,似车轮,丰富的RER、游离核糖体、高尔基复合体,由B淋巴细胞接受抗原刺激转化而来功能:产生抗体,参与机体体液免疫反应④肥大细胞:沿血管成群分布,含异染性颗粒,有特殊染色功能:内含白三烯、组胺(与过敏反应有关)、肝素(具有抗凝血作用)3.蛋白多糖:由蛋白质和糖胺多糖结合而成。
组织学与胚胎学复习重点注:加★的为老师在最后一节课划的重点,其余为每章结束时老师给出的“本章重点”。
由于整理时间有限,所以难免会有遗漏及错误之处,请大家以此资料为辅,以书本为主,望各位谅解!第一章绪论1、人体组织可归类为上皮组织、结缔组织、肌肉组织和神经组织等4种基本组织2、光学显微镜(简称光镜,LM)的分辨率约为0.25μm,光镜所观察的机体微结构称显微结构;电子显微镜(简称电镜,EM)的分辨率为0.2nm,电镜下所观察的微细结构称超微结构★3、组织学经典的标本处理技术为石蜡切片法和苏木素—伊红染色法(简称HE染色)细胞核被苏木素染成紫蓝色,细胞质和细胞间质被伊红染成粉红色4、凡是与碱性染料(苏木素等)有较强亲和力的结构特性,称嗜碱性;凡与酸性染料(伊红等)有较强亲和力的结构特性,称嗜酸性;凡与碱性和酸性染料都缺乏亲和力的结构特性称中性5、电镜下,凡被较多金属盐染色的微细结构图像较暗,称电子密度高;反之,则称电子密度低第二章细胞1、细胞膜的化学成分:细胞膜的化学组成主要是脂类、蛋白质和糖类,此外还含有水、无机盐、金属离子2、液态镶嵌模型:类脂排列成双分子层,蛋白质通过共价键与其结合,构成膜的主体;糖类通过共价键与膜的某些类脂或蛋白质结合组成糖脂或糖蛋白★3、各个细胞器的功能:线粒体:细胞的能量代谢中心核糖体:游离型:主要合成细胞自身的结构蛋白质附着型:主要合成细胞向外输出的分泌蛋白质内质网:糙面:主要合成分泌蛋白质光面:在不同种类的细胞里,光面内质网因含有不同的酶类而功能各异高尔基体:主要功能是对来自糙面内质网的蛋白质进行加工、修饰、糖化和浓缩,最终形成分泌颗粒排到细胞外溶酶体:可以分为初级、次级溶酶体以及残余体,是细胞内消化作用的主要场所过氧化物酶体:主要功能是分解代谢产物,通过水解H2O2产生水,最终保护细胞中心体:主要参与细胞分裂时纺锤体的形成和染色单体的分离,并和纤毛、鞭毛等结构的形成和运动有关细胞骨架:包括微丝、微管和中间体,和细胞的特定形状以及运动有关4、染色体的基本结构单位:核小体染色体的不同的存在形式:常染色质、异染色质和染色体是同一物质在细胞周期中不同功能状态的存在形式5、核仁的功能:参与核糖体的合成第三章上皮组织1、内皮:分布在心、血管或淋巴管腔面的单层扁平上皮称内皮间皮:分布在胸膜、腹膜、心包膜及某些器官表面的单层扁平上皮称间皮2、上皮组织的分类:上皮组织可以分为被覆上皮、腺上皮、感觉上皮等。
与其它学科的关系:分子生物学生物物理学细胞生物学免疫学生理学组织学病理学生物化学肿瘤学生殖医学环境毒理一.上皮组织特点1 细胞形状规则,密集排列成层或成膜,细胞外基质少。
2覆盖在身体的外表面或衬帖在各种管、腔、囊的内表面。
3 上皮有极性,分游离面和基底面。
4有基膜,借基膜与结缔组织相连。
5无血管,无淋巴管,营养靠结缔组织中的血管渗透。
6 有丰富的神经末梢。
(多为感觉神经末梢)1)被覆上皮;2)腺上皮;分类3)感觉上皮:嗅上皮,味蕾,视网膜,听觉、位觉感受器4)肌上皮;5)生殖上皮1)保护、吸收、分泌、排泄功能2)感觉功能3)生殖功能4)收缩功能一、被覆上皮(一)类型和结构单层扁平上皮单层单层立方上皮按其排列层次及单层柱状上皮细胞形态可分为假复层纤毛柱状上皮复层扁平上皮复层复层柱状上皮变移上皮1. 单层扁平上皮(单层鳞状上皮)结构:表面观:细胞呈多边形或不规则形侧门观:细胞扁薄,核扁圆形,位于中央。
分布:∫衬帖在心血管和淋巴管腔面的单层扁平上皮, 称内皮;∫衬于胸膜、腹膜和心包膜表面的单层扁平上皮, 称间皮功能:滑润2.单层立方上皮结构:表面观:细胞呈六角形或多边形侧面观:细胞立方形,核圆居中分布:肾小管上皮、甲状腺滤泡上皮等功能:吸收和分泌3.单层柱状上皮组织:由一层柱状细胞紧密排列而成,有的夹有杯状细胞结构:柱状细胞:核长圆形,位于细胞基底部杯状细胞:形似高脚酒杯,胞浆充满粘原颗粒,内含粘蛋白和水,水化为粘液分布:1)胃肠道粘膜,在肠粘膜上皮夹有杯状细胞。
2)在子宫、输卵管腔面单层柱状上皮的游离面上有纤维,称单层纤毛柱状上皮。
功能:保护、分泌、吸收等4.假复层纤毛柱状上皮组成:四种细胞柱状细胞:上有纤毛能摆动,顶天立地杯状细胞:高脚酒杯梭形细胞:织布梭子锥体细胞:脚踏实地5.复层扁平上皮(复层鳞状上皮)组成:表层:数层细胞为扁平状中间层:由浅入深分别为梭状和多变形细胞基底层:一层立方形或矮柱细胞,有较强的分裂增殖的能力分布:1)在皮肤表层的复层扁平上皮,浅层细胞已无细胞核,胞质中充满角蛋白,形成角质层,这种上皮称角化的复层扁平上皮;2)衬帖在口腔和食管等腔面的复层扁平上皮,浅层细胞是有核的活细胞,含角蛋白少,称未角化的复层扁平上皮。
《组织学与胚胎学》复习资料 名解&(简答题)&问答题 第一章、上皮组织 名解: 1、内皮:分布在心脏、血管、淋巴管腔面的单层扁平上皮 2、间皮:分布在胸膜、腹膜、心包膜表面的单层扁平上皮 3、基膜:上皮细胞的基底面与深部结缔组织间的一层薄膜样结构 4、微绒毛:细胞游离面的细胞膜与质共同向外形成的指状突起
第二章、结缔组织 名解: 1、组织液:由毛细血管动脉端渗出的部分血浆成分,含有血液中多种营养成分 2、骨单位:骨单位(哈弗氏系统)是长骨干起支持作用的主要结构单位,位于内外骨板间,数量较多,呈筒状,由10~20层同心圆排列的骨板构成 问答: 1、结缔组织的基本特征: 1 细胞少,间质多 ﻩ2 无极性地分散于细胞间质中 3 包括纤维、基质、组织液 ﻩ4 有连接、支持、防御、保护、营养、运输、修复的作用 2、比较胶原纤维和弹性纤维的异同点: 1 抗拉/弹性 ﻩ2 量多/量少 3 粗细不等/细 3、描述巨噬细胞的光镜结构&功能: 结构: 1 核小(圆形或肾形) 2 有较长的伪足,形态不定 3 胞浆丰富嗜酸 功能: 1 趋化运动 ﻩ2 吞噬作用 ﻩ3 免疫应答 ﻩ4 分泌作用 4、长骨骨干的组织结构: 骨松质、骨膜、关节软骨、骨髓 骨密质: 1 环骨板 2 骨单位(构成骨板) ﻩ 3 间骨板 4 骨内外膜 ﻩ 5 中央管,穿通管
第三章、血液 名解: 1、 血浆:血液离心后的上层淡黄色液体,约占血液总量的55%,PH为7.3~7.4,渗透压为313mOsm,包含水、无机物、有机质 问答: 1、光镜下红细胞的结构特点: 1 圆形,两面凹,中央浅红,周围深红 ﻩ2 无细胞核,无细胞器 ﻩ3 有一定的可塑性 2、光镜下中性粒细胞与嗜酸性粒细胞的异同点(详见下): 异: 1 数量:多/少 2 胞质:细小/粗大 同: 1 直径相似 2 分叶核数量相近 3、比较光镜下单核细胞与淋巴细胞的异同点(详见下): ﻩ异: 1 数量:3~8% / 20~30% ﻩ2 体积:14~25μm / 5~8μm 3 胞核: 核形态多样 / 核大,核质比=9∶1 ﻩ同: 含嗜天青颗粒
第四章、肌组织 名解: 1、肌节:相邻两条Z线间的肌原纤维,1/2的I带+A带+1/2的I带 2、横小管:由肌膜向肌浆内凹陷的小管,垂直肌膜表面 3、三联体:有每条横小管与其两侧的终池所组成 4、闰盘:心肌细胞的连接 问答: 1、骨骼肌纤维的光镜结构: 1 细长圆柱状,直径10~100μm,长1~40mm ﻩ2 肌膜外有基膜,有几十~几百个细胞核,位于肌膜下方 3 肌浆内有大量肌原纤维,纤维间有大量线粒体 4 纤维具有明(I带——Z线)暗(A带——H线——M线)带 2、骨骼肌纤维的超微结构: 1 肌原纤维:粗(肌球蛋白)、细(肌动蛋白、钙蛋白、原肌球蛋白)肌丝组成 ﻩ2 横小管 3 肌浆网
第五章、神经组织 名解: 1、 郎飞结:轴突各节段间无髓鞘处的弧形缩窄区 2、 结间体:相邻两郎飞结间的一段神经纤维 3、 神经纤维:由神经元长突起和包在外的神经胶质细胞,在中枢形成传导束,在周围形成神经,功能是传导冲动 4、 神经末梢:神经纤维末梢在组织、器官内形成的有特殊结构与功能的部分 5、 运动终板:分布在骨骼肌纤维处的运动末梢 问答: 1、什么是突触,并进行分类: 突触:神经元与神经元或非神经元之间的特化的细胞连接 分类:化学、电、混合 2、化学突触的超微结构: 1 前成分:突触小泡、突触前膜 ﻩ2 后成分:突触后膜、化学门控通道 ﻩ3 间隙: 3、神经纤维的构成和分类: 1 构成:神经元的长突起和包在其外面的神经胶质细胞组成,在中枢神经系统中由少突胶质细胞构成,在周围神经系统中有神经膜细胞构成 2 分类:根据神经胶质细胞是否形成髓鞘结构,分为有髓神经纤维和无髓神经纤维
第六章、循环系统 名解: 1、 血窦:也称窦状毛细血管,管径较宽,大小形状不规则,内皮细胞间间距较大,基膜不连续或完全缺如的毛细血管 问答: 1、光镜下中动脉的管壁结构: 1 内膜:由内皮、内皮下层、内弹性膜构成 ﻩ2 中膜:10~40层平滑肌,由弹性纤维、胶原纤维构成 ﻩ3 外膜:由疏松结缔组织构成 2、简述各种毛细血管管壁特征及分布范围: 管壁特征: 1 连续毛细血管:内皮细胞相互连续,细胞连接紧密,封闭了细胞间隙。基膜完整。分布于结缔组织、肌组织、中枢神经系统、胸腺和肺。参与了血-脑屏障等屏障性结构的组成。 2 有孔毛细血管:一层紧密连接的内皮细胞和连续的基膜,内皮细胞不含核的部分较薄。分布于胃肠粘膜、某些内分泌腺和肾血管球 ﻩ3 血窦:内皮细胞有较大的间隙,基膜不连续或完全缺如。分布于肝脏、脾、骨髓
第七章、免疫系统 名解: 1、单核吞噬细胞:单核细胞和由其分化而来的具有吞噬功能的细胞的统称 2、淋巴小结:与周围的界限清楚,由B细胞密集而成,也含有一定量的Th细胞 3、血-胸腺屏障:连续型毛细血管内皮、内皮基膜巨噬细胞血管间隙、胸腺上皮的基膜 4、副皮质区:位于皮质深层,由T细胞聚成的弥散淋巴组织 问答: 1、淋巴结皮质的结构和功能: 1 浅层皮质:由淋巴小结及小结间的薄层弥散淋巴组织组成,为皮质的B细胞区 ﻩ2 副皮质区:位于皮质的深层,为较大片的弥散淋巴组织,主要有T细胞聚集而成 3 皮质淋巴窦:是被摸下方和与其连同的小梁周围的淋巴窦分别称为被膜下窦和小梁周窦 ﻩ功能:巨噬细胞清除进入腔内细菌、异物,捕获抗原物质 2、淋巴小结光镜结构: 1 暗区:由许多刚转化的体积较大的B细胞核部分Th细胞组成,细胞嗜碱性强而着色较深 ﻩ2 明区:主要由中等大小的B细胞、滤泡树突状细胞核巨噬细胞 ﻩ3 小结帽:一层密集的小淋巴细胞,含幼浆细胞、初始B细胞和记忆性B细胞
第八章、消化系统 名解: 1、ﻩ肠绒毛:肠上皮+固有层向肠壁突出的细小突起 2、ﻩ中央乳糜管:肠绒毛中轴固有层12条的纵行毛细淋巴管,运送肠胃上皮细胞吸收的乳糜微粒 3、ﻩ门管区:相邻肝小叶间呈三角形或不规则的结缔组织小区 4、 窦周隙:肝细胞与血液之间的物质交换场所,位于内皮细胞与肝细胞间的狭小间隙 问答: 1、 肝细胞各邻接面的超微结构: 1 肝细胞的连接面:紧密连接、桥粒连接 ﻩ2 肝血窦面:有发达的微绒毛,内皮细胞有间隙,内皮外无基膜 ﻩ3 胆小管面:有发达的微绒毛,紧密连接、桥粒连接、具有微绒毛,相邻肝细胞角膜局部凹陷形成胆小管 2、 肝血窦和窦周隙的结构和功能意义: ·肝血窦的结构:位于肝板之间,有小叶间动脉、静脉终末支将血液汇入,汇入中央静脉,肝血窦壁由内皮细胞围成 ·功能:有利于肝细胞与血流之间进行物质交换。其内有肝巨噬细胞,为肝内重要的防御装置 ·窦周隙的结构:位于内皮细胞与肝细胞之间,有贮脂细胞 ·功能:利于物质交换,贮存维生素A 3、 肝小叶的组成、结构、功能: ·组成:肝板、肝血窦、胆小管围绕中央静脉而成的 ·结构:中央有长轴中央静脉,周围有放射状排列的肝板,肝板间有肝血窦,相邻肝细胞局部胞膜内陷形成胆小管 ·功能: 1 接受小叶间静脉、动脉血,加工肠胃吸收的营养物质,由小叶下静脉运出 2 肝细胞合成胆汁后汇聚胆小管,由小叶间胆管运出
第九章、呼吸系统 名解: 1、气血屏障:肺泡内气体与肺泡隔毛细血管内气体进行交换所通过的结界 2、肺泡隔:相邻肺泡间的薄层结缔组织,属肺间质 问答: 1、ﻩ肺气壁的结构特点及其功能的关系: 结构特点:黏膜(纤毛细胞、杯状细胞)、粘膜下层(含混合性气管腺)、外膜(有C型透明环状软骨) ﻩ·功能: 黏膜:清除异物,构成黏液屏障 外膜:支撑作用,保持气道通畅,有助于免疫作用,有利于清除痰液 2、 肺内导气部的组成及结构变化规律: ﻩ组成:支气管、小支气管、细支气管、终末细支气管 ﻩ变化规律: 1 管壁:厚——薄 2 杯状细胞:多——少——无 ﻩ 3 气管腺:多——少——无 4 软骨片:多——少——无 ﻩ5 平滑肌:无或少——多——完整环形 3、ﻩ气血屏障的组成和功能: ·组成:肺泡表面液体层、Ⅰ型肺泡细胞和基膜、薄层结缔组织、连续毛细血管基膜和内皮 ·功能:有利于气血交换
第十章、泌尿系统 名解: 1、 肾单位:由肾小体和肾小管组成,是尿液形成的结构和功能单位 2、 滤过屏障:血浆经过的有孔内皮、毛细血管基膜、足细胞裂孔膜这三层结构的总称 3、 致密斑:远端小管曲部在近血管极一侧的细胞呈高柱状紧密排列,形成的直径40~70μm的椭圆形隆起,约有20~30个细胞组成 问答: 1、 近端小管曲部管径粗,官腔窄而不规则,胞界限不清的原因: 1 表面积大,有利于重吸收 ﻩ2 完成钠离子、钾离子的主动运输
第十一章、男性生殖系统 名解: 1、 血-睾屏障(血-生精屏障):包括血管内皮和基膜、结缔组织、生精上皮界膜、支持细胞紧密连接 问答: 1、 精子形成的主要变化: 精子形成:单倍体精子细胞经过复杂的变化,由圆形逐渐转化为蝌蚪形的精子过程 主要变化: